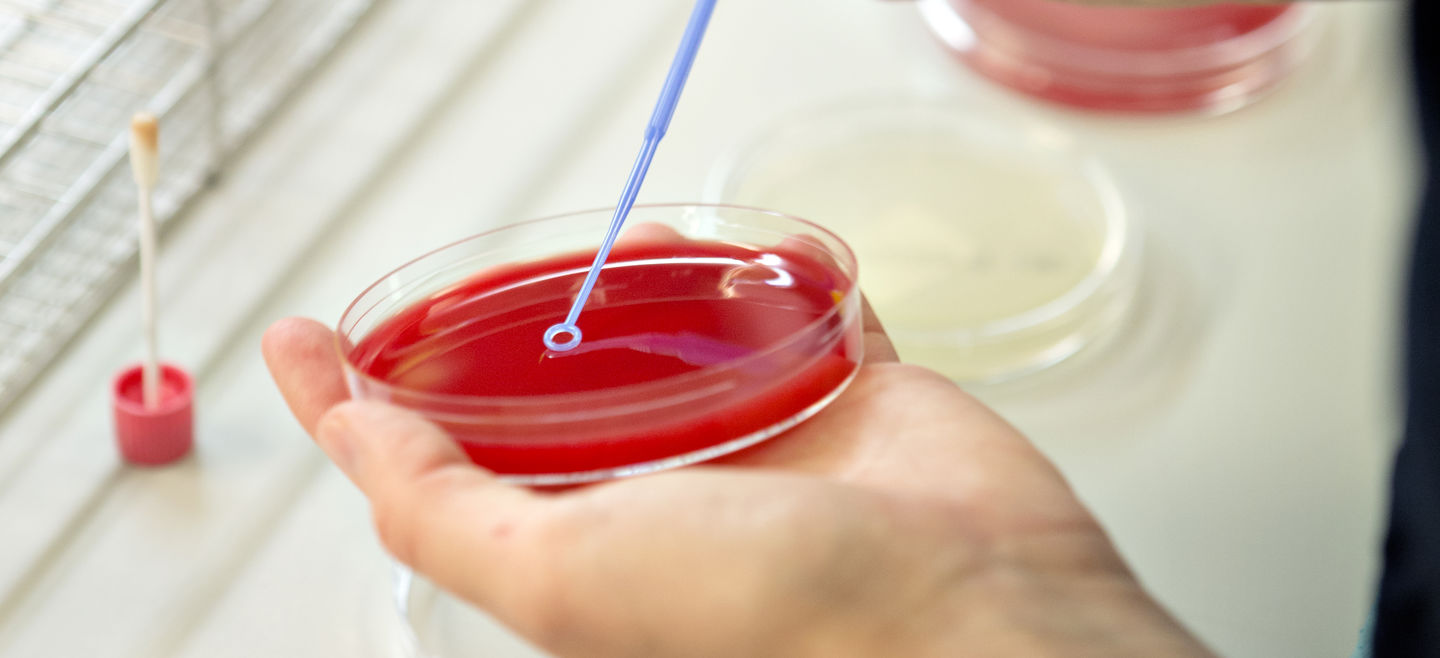
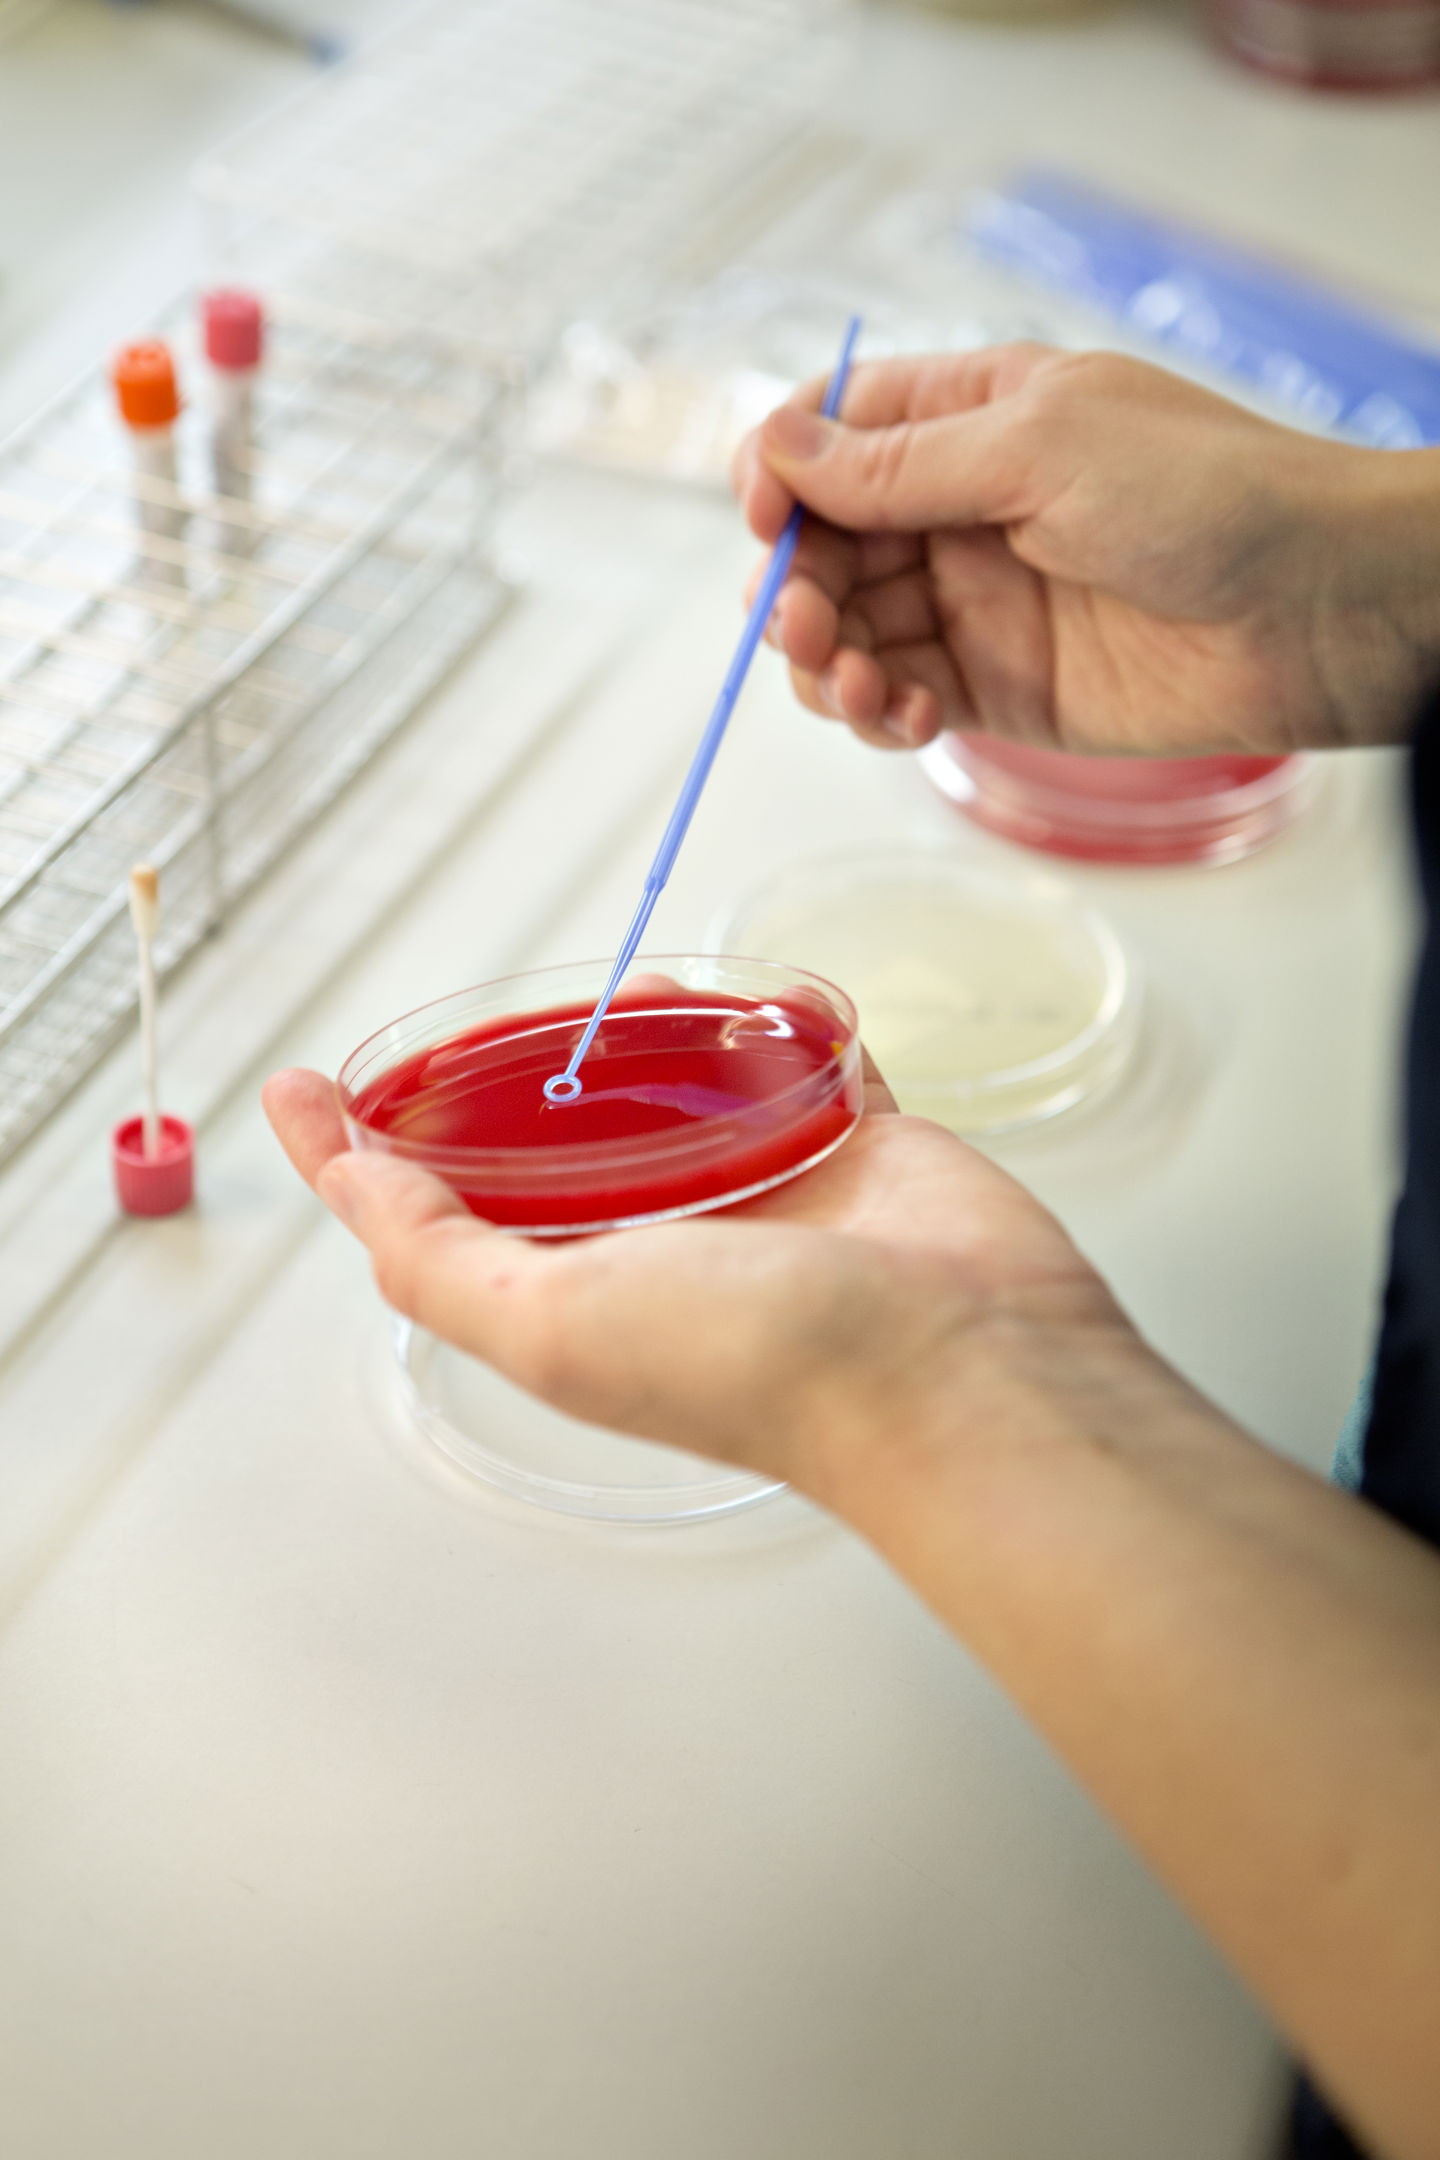

Webinar
Webinar: Anti-microbial Resistance: innovation challenges for viable futures
- 10. JUN 2025 kl. 14:00 - 15:30
- Free
Sundhed
Sundhed
Event Description
Historically, antibiotics transformed health and healthcare in many parts of the world; however, serious issues have emerged surrounding antimicrobial resistance (AMR) (including antibiotic resistance), which is now one of the top 10 global health threats. One of the challenges associated with AMR is the failure of innovation in the development of antibiotics, which has a number of political-economic drivers.
This webinar brings together experts in AMR and antibiotic innovation from across academic, not-for-profit / NGO, and private /commercial sectors to discuss innovation challenges related to antibiotic R&D and AMR, the different ways divers organizations seek to address those challenges, and what might a viable future look like for addressing AMR.
Next to presentations from the below experts, significant time will be provided for discussion / questions-and-answers.
The webinar is hosted by VIVE in collaboration with The Global Pharmaceutical and Society Studies (GPSS) Network.
Date and time
Tuesday 10. June 2025 at 14:00 to 15:30 CET.
Registration Deadline
Tuesday 10. June 2025 at 12:00 CET.
Presenters:
Christian Haddad, PhD
Assistant Professor & Principal Investigator ALTERBIOTIC (ERC)
Sociology | Science & Technology Studies
University of Vienna
Assistant Professor & Principal Investigator ALTERBIOTIC (ERC)
Sociology | Science & Technology Studies
University of Vienna
Rohit Malpani, PhD
Senior Advisor
Global Antibiotic Research and Development Partnership (GARDP)
Senior Advisor
Global Antibiotic Research and Development Partnership (GARDP)
Vasanthi Ramachandran Ph.D
Vice President, Collaborations
BUGWORKS Research India Pvt. Ltd.
Vice President, Collaborations
BUGWORKS Research India Pvt. Ltd.